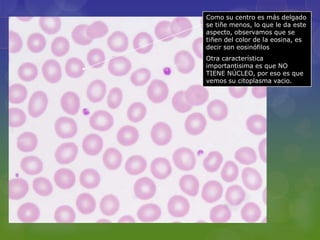
Como su centro es más delgado
se tiñe menos, lo que le da este
aspecto, observamos que se
tiñen del color de la eosina, es
decir son eosinófilos
Otra característica
importantisima es que NO
TIENE NÚCLEO, por eso es que
vemos su citoplasma vacio.
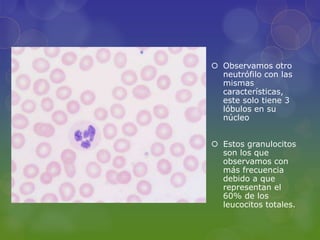
 Observamos otro
  neutrófilo con las
  mismas
  características,
  este solo tiene 3
  lóbulos en su
  núcleo


 Estos granulocitos
  son los que
  observamos con
  más frecuencia
  debido a que
  representan el
  60% de los
  leucocitos totales.
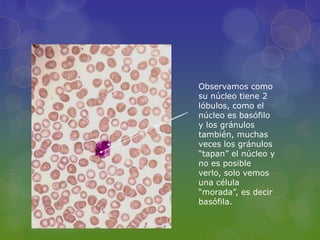
Observamos como
su núcleo tiene 2
lóbulos, como el
núcleo es basófilo
y los gránulos
también, muchas
veces los gránulos
“tapan” el núcleo y
no es posible
verlo, solo vemos
una célula
“morada”, es decir
basófila.
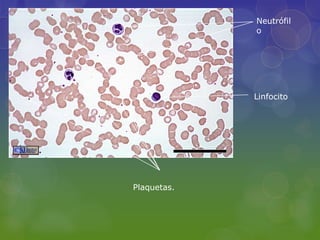
Neutrófil
             o




             Linfocito




Plaquetas.

Este documento describe los componentes de la sangre, incluyendo los elementos figurados y el plasma sanguíneo. Los elementos figurados son los glóbulos rojos, glóbulos blancos y plaquetas. Los glóbulos rojos transportan oxígeno y dióxido de carbono, mientras que los glóbulos blancos forman parte del sistema inmunitario. El plasma sanguíneo es el componente líquido de la sangre y contiene proteínas, gases, electrolitos y otras sustancias.